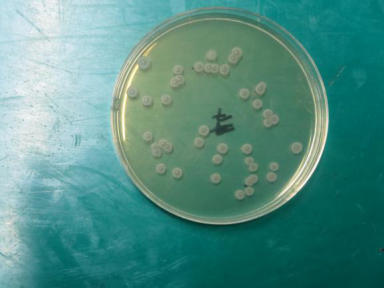
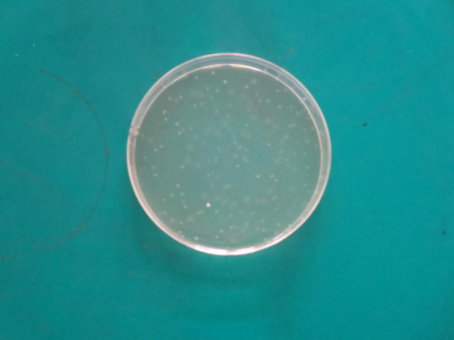
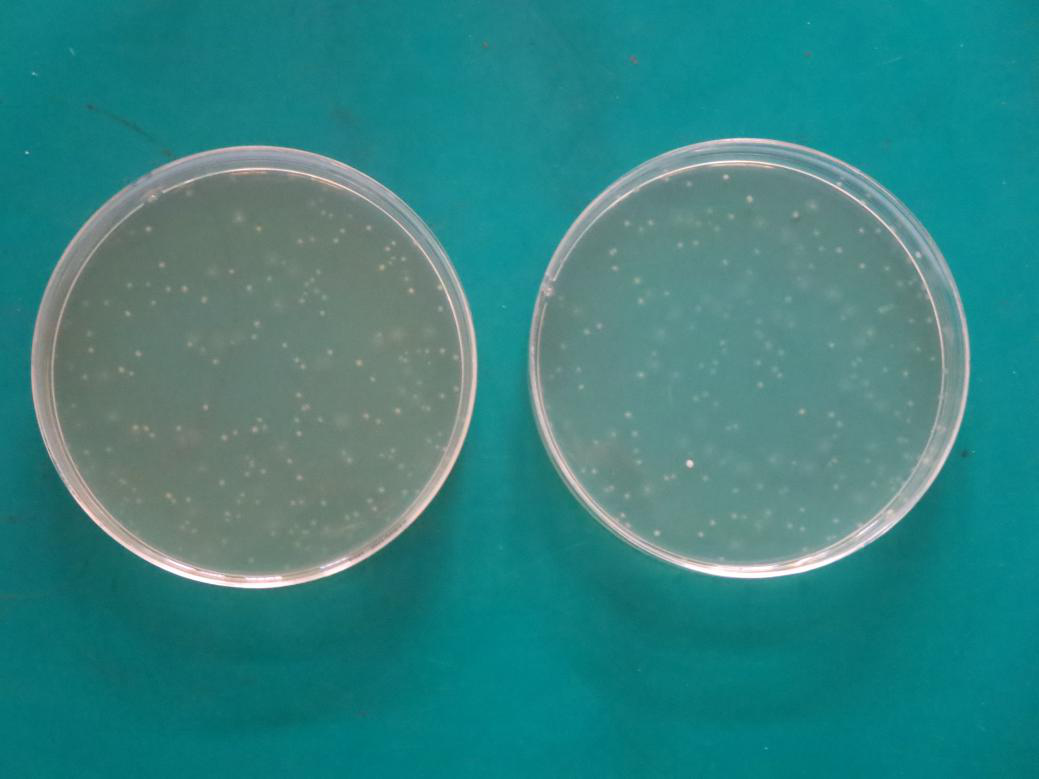

海博微信公众号
海博微信公众号
 海博天猫旗舰店
海博天猫旗舰店


 海博微信公众号
海博微信公众号
 海博天猫旗舰店
海博天猫旗舰店




一、实验名称:
枯草芽孢杆菌在TSA HB0177-1平板上的生长实验。
二、实验原理:
通过涂布法和倾注法来观察枯草芽孢杆菌CMCC(B)63501在TSA平板上的生长情况和影响生长因素。
三、实验步骤:
1.将枯草芽孢杆菌CMCC(B)63501稀释到10-6浓度吸取100微升涂布到TSA平板上,以BD公司TSA和我公司普通TSA为对照。
2.将枯草芽孢杆菌CMCC(B)63501稀释到10-7浓度吸取1毫升正常倾注到TSA平板上,以BD公司TSA为对照。
3.将枯草芽孢杆菌CMCC(B)63501稀释到10-7浓度吸取1毫升倾注到TSA平板上,上层覆盖时培养基厚度加为正常量的1.5倍,以BD公司TSA为对照,来证实氧气含量对于生长的影响。
四、实验结果:
1.涂布法:HB0177-1上平均生长45个菌落(如图一),BD TSA上平均生长52个菌落(如图二),普通TSA上平均生长49个菌落(如图三)。
图一、HB0177-1

图二、BD

图三、普通
2.普通倾注法:两个平板生长的菌落数无明显差别。
图四、0177-1

图五、BD
3.加厚倾注法:0177-1的加厚倾注法(图六左)和普通倾注法(图六右)菌落数无明显差别,BD公司TSA的加厚倾注法(图七左)和普通倾注法(图七右)菌落数无明显差别。
图六、0177-1

图七、BD
五、结论:
我公司0177-1产品上枯草芽孢杆菌CMCC(B)63501生长状况良好,与普通TSA和进口TSA平板的生长状况无明显差别。且在加厚覆盖层的情况下,生长情况依然不受影响。
注:本文属海博生物原创,未经允许不得转载。
上一篇:支原体简介和常见问题
下一篇:影响培养基灭菌效果的因素



